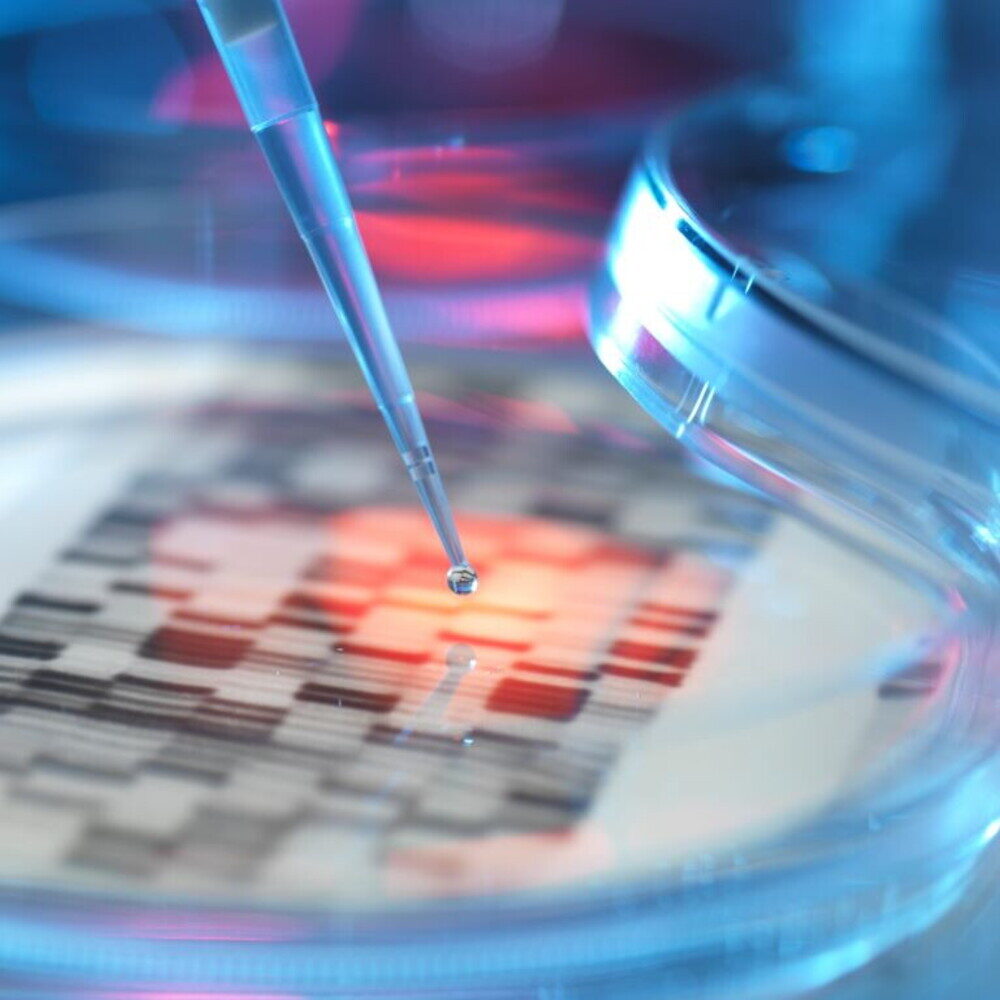
Garlasco: compatibilità DNA Y in 12 marcatori su 16 spiegata

Nel complesso mondo delle indagini forensi, l’analisi del DNA Y rappresenta uno strumento potente, soprattutto quando si tratta di ricostruire contesti familiari. Lo dimostra il caso di Chiara Poggi, dove gli esami hanno rivelato una compatibilità genetica significativa: ben 12 marcatori su 16 tra il DNA trovato sotto le sue unghie e quello della linea maschile della famiglia Sempio.
La perita Denis Albani, durante l’incidente probatorio, ha fornito una spiegazione chiara e fondamentale: un’aplotipo, come quello analizzato, non può identificare un singolo individuo. Piuttosto, serve a delineare un contesto familiare di appartenenza. In parole più semplici, il test non dice “questo DNA è di Tizio”, ma indica con alta probabilità che appartiene a un uomo della stessa linea familiare.
Cos’è il DNA Y e a cosa serve
Il DNA Y è un tipo di DNA nucleare che viene trasmesso esclusivamente di padre in figlio. A differenza del DNA mitocondriale, che traccia la linea materna, il cromosoma Y è fondamentale per ricostruire la discendenza maschile di una famiglia. Viene comunemente utilizzato nei test di paternità e, in ambito forense, per collegare un profilo genetico a un specifico gruppo familiare.
Nel caso in esame, gli accertamenti hanno quindi stabilito un legame tra il DNA Y della famiglia Sempio e il materiale genetico recuperato dalle unghie di Chiara Poggi. Questo risultato, sebbene non sia una prova certa dell’identità di una singola persona, fornisce un indizio investigativo di enorme rilevanza, contribuendo a “chiudere il cerchio” delle indagini.
Le criticità dell’analisi forense
Nonostante l’importanza del ritrovamento, la perita Albani non ha mancato di sottolineare le criticità. L’analisi biostatistica su profili di DNA Y misto, ovvero proveniente da più individui, è una tematica relativamente nuova. Gli strumenti a disposizione per l’interpretazione sono ancora limitati rispetto a quelli utilizzati per il DNA autosomico, che è la prassi consolidata.
Questo significa che, pur in presenza di concordanze numeriche come i 12 marcatori, i profili non sono sempre “consolidati” o “corroborati” da sessioni di analisi che possano confermarne la certezza assoluta. La valutazione, in questi casi, rimane un’interpretazione statistica che, seppur solida, deve essere contestualizzata con tutte le informazioni investigative a disposizione.